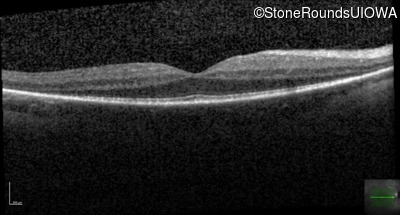
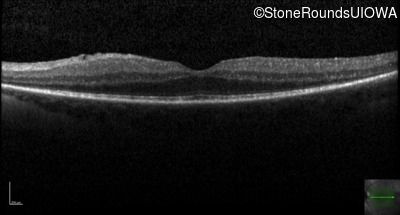
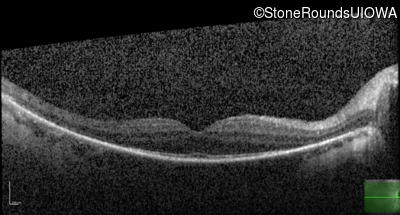
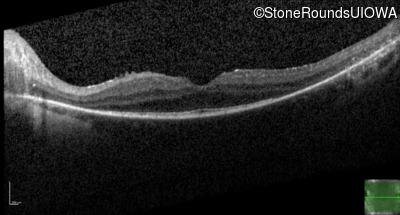
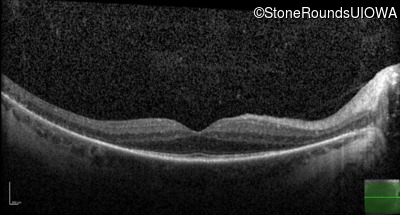
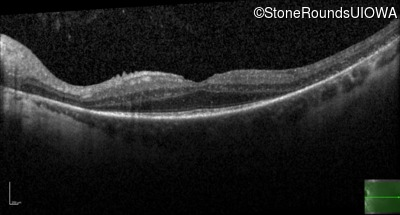
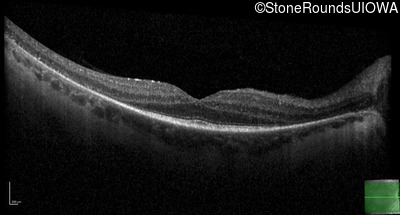
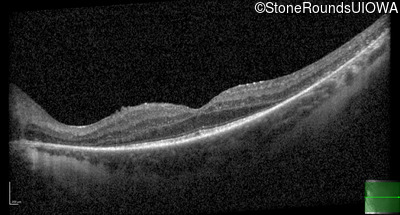
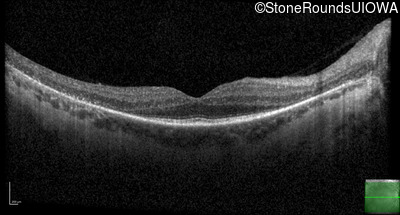
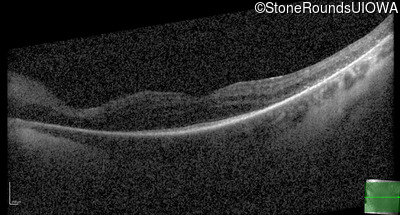

Case
SR144
Student Mode
AR Retinitis Pigmentosa (IA1aiii)
Male
Male
Hidden
SR144
Student Mode
AR Retinitis Pigmentosa (IA1aiii)
Male
Male
| Age at visit: 33 years |
| Age at visit: 37 years |
| Age at visit: 38 years |
Diagnosis & molecular findings
| Disease | Gene | Allele 1 variant(s) | Allele 2 variant(s) | Inheritance mode |
|---|---|---|---|---|
| AR Retinitis Pigmentosa | USH2A | IVS10-2 A>G | Cys3358Tyr TGC>TAC | AR |
Disease:
Gene:
Allele 1:
IVS10-2 A>G
Allele 2:
Cys3358Tyr TGC>TAC
Inheritance:
AR